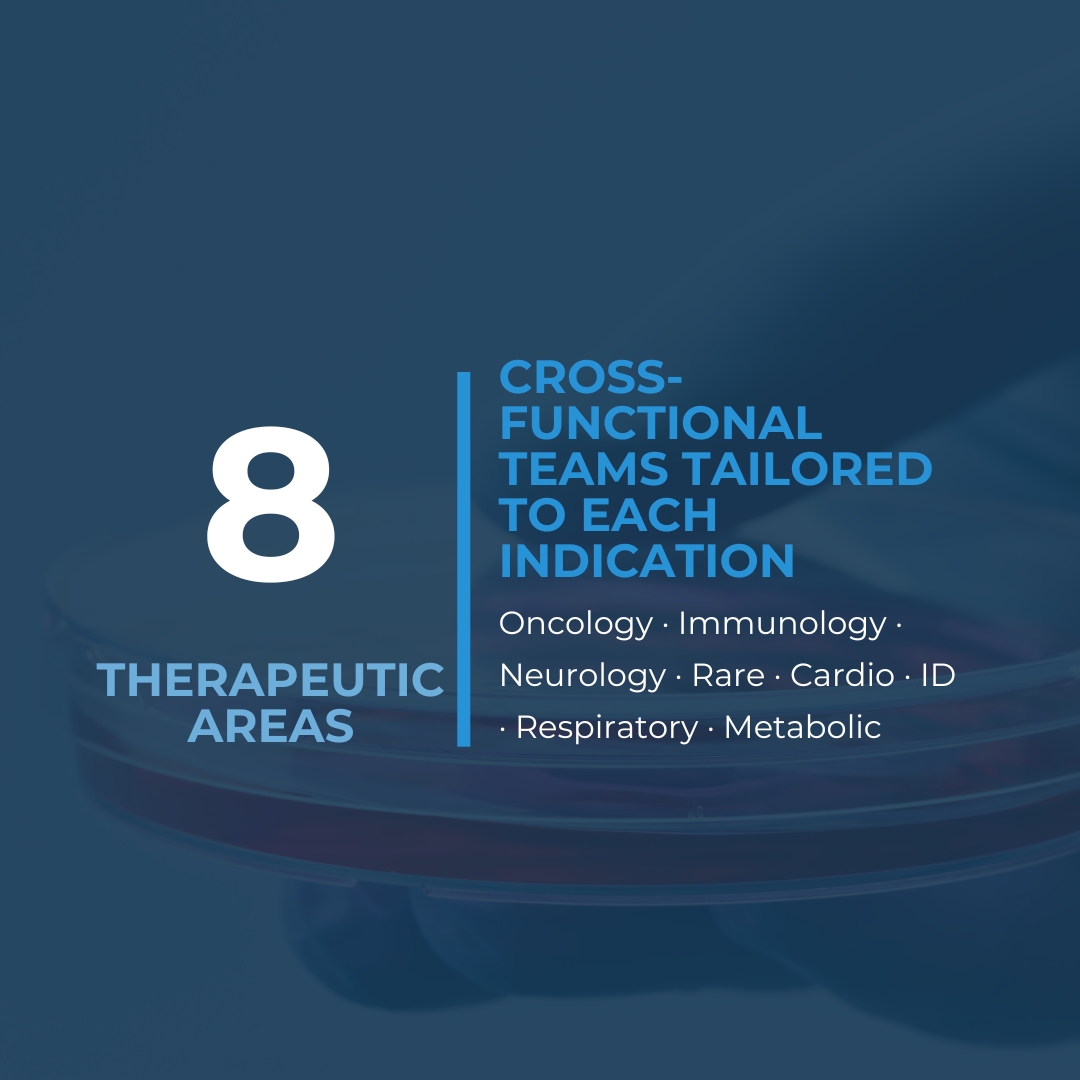

Geistek is your trusted partner combining scientific rigor and regulatory expertise. Our 360° model guides companies from laboratory to market with confidence and compliance.




We support biotech, pharma, and medical device companies across the full development pathway, from preclinical research to market approval, with scientific rigor, regulatory certainty, and operational excellence.

Global submissions, EMA/FDA pathways, compliance strategies.

Clinical and regulatory documents: protocols, CSRs, CERs, dossiers.

Tailored study design, endpoint strategy, feasibility & indication planning.

Full-service trial operations from Phase I–IV, site & patient management.

EDC setup, data cleaning, analysis, advanced statistics & AI models.
We support biotech, pharma, and medical device companies across the full development pathway, from preclinical research to market approval, with scientific rigor, regulatory certainty, and operational excellence.
At Geistek, we bring together proven expertise across biotech, pharma, and medical devices. Our track record demonstrates our ability to deliver complex projects with scientific rigor and regulatory precision.

| Cookie | Duración | Descripción |
|---|---|---|
| cookielawinfo-checkbox-analytics | 11 months | This cookie is set by GDPR Cookie Consent plugin. The cookie is used to store the user consent for the cookies in the category "Analytics". |
| cookielawinfo-checkbox-functional | 11 months | The cookie is set by GDPR cookie consent to record the user consent for the cookies in the category "Functional". |
| cookielawinfo-checkbox-necessary | 11 months | This cookie is set by GDPR Cookie Consent plugin. The cookies is used to store the user consent for the cookies in the category "Necessary". |
| cookielawinfo-checkbox-others | 11 months | This cookie is set by GDPR Cookie Consent plugin. The cookie is used to store the user consent for the cookies in the category "Other. |
| cookielawinfo-checkbox-performance | 11 months | This cookie is set by GDPR Cookie Consent plugin. The cookie is used to store the user consent for the cookies in the category "Performance". |
| viewed_cookie_policy | 11 months | The cookie is set by the GDPR Cookie Consent plugin and is used to store whether or not user has consented to the use of cookies. It does not store any personal data. |